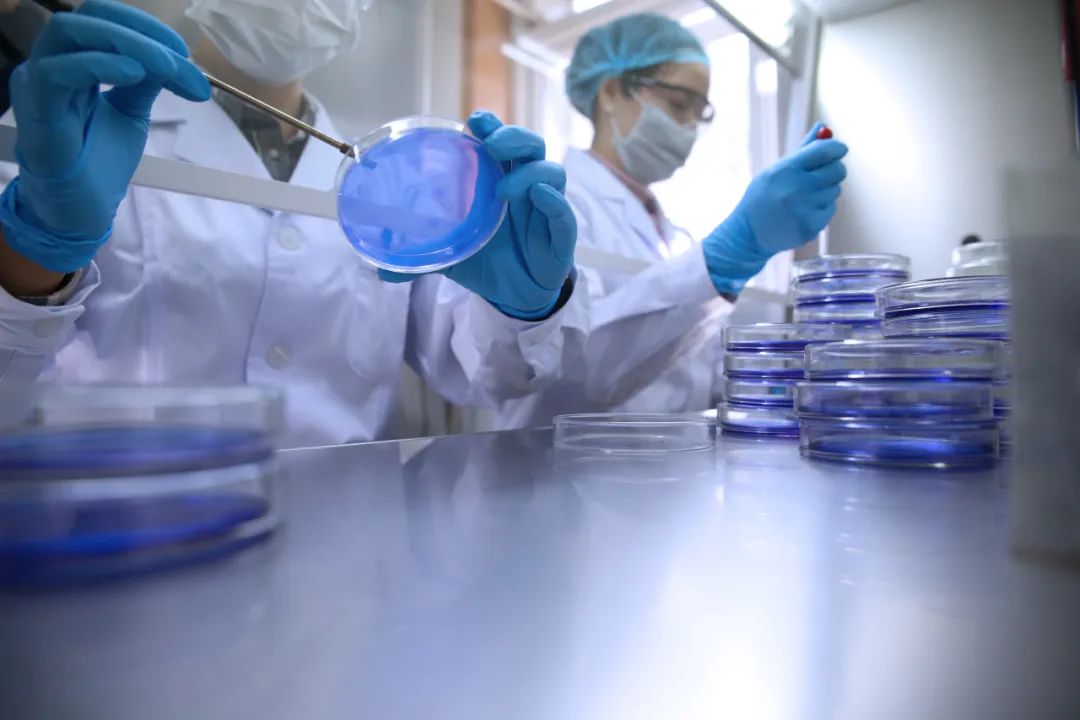
图片

来源 :国检集团CTC2025-03-18
中关村汇智抗菌新材料产业技术创新联盟(CIAA)是国内最具影响力和技术能力的抗菌检测实验室间比对试验组织单位之一。国检集团在最近的CIAA抗菌检测实验室间比对试验中荣获“满意”评价,并入选2025年度合规抗菌检测实验室推荐名录。国检集团已多年连续入选CIAA合规实验室推荐名录,未来将继续依托规范化的管理、优质的服务和过硬的技术,为社会提供“客观、公正”的检测。

国检集团微生物实验室
实验室自2004年起通过中国合格评定国家认可委员会(CNAS)和国家计量认证(CMA)二合一评定,是国内最早从事材料抗微生物性能评价的实验室之一,同时也是 CIAA的理事单位。主要从事抗菌、防霉、抗藻检测、抗病毒检测、菌种鉴定、微生物净化效率评价等。